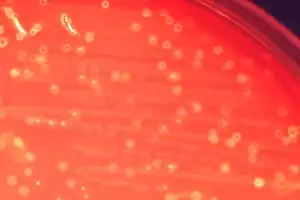

Streptococcus anginosus
| Streptococcus anginosus | ||||||||||||
|---|---|---|---|---|---|---|---|---|---|---|---|---|
Kolonien von Streptococcus anginosus auf Blutagar | ||||||||||||
| Systematik | ||||||||||||
| ||||||||||||
| Wissenschaftlicher Name | ||||||||||||
| Streptococcus anginosus | ||||||||||||
| (Andrewes & Horder 1906) Smith & Sherman 1938 |
| Klassifikation nach ICD-10-GM | |
|---|---|
| B95.48[1] | Sonstige näher bezeichnete Streptokokken als Ursache von Krankheiten, die in anderen Kapiteln klassifiziert sind |
| ICD-10 online (GM-Version 2024) | |
Streptococcus anginosus ist eine Bakterienart aus der Gattung Streptococcus (eingedeutscht: Streptokokken). Als Teil der menschlichen Bakterienflora besiedelt sie insbesondere den menschlichen Mundraum. Unter bestimmten Bedingungen kann sie als Krankheitsauslöser wirken.
Merkmale
Streptococcus anginosus sind kokkoide (rundliche), grampositive und aerotolerante Bakterien, die in Ketten wachsen. In Kultur bilden sie trockene, raue und krümelige oder glatte und weiche, weiße oder graue Kolonien mit einem Durchmesser von 1 bis 2 Millimetern. Eine Produktion von Polysaccharidkapseln ist bisher nur in einem Biovar beschrieben.
Verbreitung und Pathogenität
Streptococcus anginosus ist ein Bestandteil der Normalflora des Menschen. Er besiedelt vor allem den Mundraum, wo er die häufigste Art ist, und die oberen Partien der Atmungsorgane, daneben findet er sich jedoch auch im Verdauungstrakt und im Urogenitaltrakt.
Streptococcus anginosus kann Krankheiten auslösen, hauptsächlich eitrige Entzündungen des Urogenitaltrakts und des Verdauungstrakts, aber auch der Haut, der Knochen und des Kopfes. Bei Immundefizienten Personen können die Bakterien über den Blutkreislauf auch andere Gewebe und Organe erreichen und dort Krankheiten verursachen, so zum Beispiel im Zentralen Nervensystem, im Bauchraum oder im Blut selbst.
Eine gegebenenfalls notwendige antimikrobielle Therapie von Infektionen mit Streptococcus anginosus, S. intermedius und der S. constellatus-Gruppe erfolgt mit Antibiotika. Dazu eignen sich Penicillin, Ceftriaxon, Cefotaxim, Clindamycin und Vancomycin.[2]
Systematik
Streptococcus anginosus ist die namensgebende Art der sogenannten Anginosus-Gruppe innerhalb der Streptokokken, in die außerdem noch Streptococcus constellatus und Streptococcus intermedius gestellt werden. Die Gruppe gilt im Hinblick auf Taxonomie und Nomenklatur als schwierig und widersprüchlich, neuere Ergebnisse jedoch unterstützen die Gliederung in drei Arten. Die Gruppe wird zuweilen auch als Milleri-Gruppe bezeichnet nach der nicht mehr anerkannten Art „Streptococcus milleri“, deren Isolate durch genetische Untersuchungen als S. anginosus (bzw. in einem Fall S. intermedius) identifiziert wurden.[3]
Innerhalb der Art existieren zwei Gruppen genetischer Ähnlichkeit. Die Mehrzahl der β-hämolytischen Stämme der Lancefield-Gruppe C bildet eine der beiden Gruppen. Da sie sich jedoch biochemisch nicht eindeutig bestimmen lassen, ist diese Unterscheidung ohne taxonomische Relevanz.
Literatur
- Jeremy M. Hardie, Robert A. Whiley: The Genus Streptococcus – Oral (Chapter 1.2.2). In: Martin Dworkin, Stanley Falkow, Eugene Rosenberg, Karl-Heinz Schleifer, Erko Stackebrandt (Hrsg.): The Prokaryotes. A Handbook on the Biology of Bacteria. 3. Auflage. Volume 4: Bacteria: Firmicutes, Cyanobacteria. Springer-Verlag, New York 2006, ISBN 978-0-387-25494-4, S. 76–107, doi:10.1007/0-387-30744-3_2.
Einzelnachweise
- ↑ icdscout.de abgerufen 2020
- ↑ Marianne Abele-Horn: Antimikrobielle Therapie. Entscheidungshilfen zur Behandlung und Prophylaxe von Infektionskrankheiten. Unter Mitarbeit von Werner Heinz, Hartwig Klinker, Johann Schurz und August Stich, 2., überarbeitete und erweiterte Auflage. Peter Wiehl, Marburg 2009, ISBN 978-3-927219-14-4, S. 267.
- ↑ Robert A. Whiley: Emended Descriptions and Recognition of Streptococcus constellatus, Streptococcus intermedius, and Streptococcus anginosus as Distinct Species. In: International Journal of Systematic Bacteriology. Band 41, Nr. 1, 1991, S. 1–5, doi:10.1099/00207713-41-1-1 (englisch).